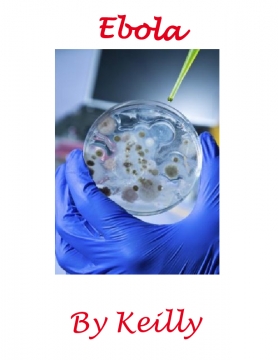

Hi my name is Keilly Alonso Riveron. I wanted to right this book because if you have Ebola i want you to be inspired by this book.This is my first time writing a book and I did it on Ebola because I want you to learn something about Ebola to just like me.I wanted to learn something new about Ebola virus so I can tell you about Ebola virus.
|
Keilly Joined: Jan-28-2016 |
Hi, my name is Keilly and I am obsessed with tumbling.Gabby Dougles inspired me to do gymnastics because I watched her movie on Netflix and she is incredible at gymnastics . She is also loving and caring because she is teaching children tumbling and she really wanted to still be in gymnastics.Also I love the bars. That is my favorite event because you can do a lot of tricks like the windmill,pull over,back roll and front roll.